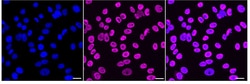
Invitrogen TAF15 Recombinant Rabbit Monoclonal Antibody (24GB1830) 20 &mu;L;

missing translation for 'onlineSavingsMsg'
Learn More
Learn More
Invitrogen™ TAF15 Recombinant Rabbit Monoclonal Antibody (24GB1830)
Rabbit Recombinant Monoclonal Antibody
Brand: Invitrogen™ MA557759
This item is not returnable.
View return policy
Description
TAF15 Recombinant Monoclonal Antibody for Western Blot, ICC/IF, Flow
Initiation of transcription by RNA polymerase II requires the activities of more than 70 polypeptides. The protein that coordinates these activities is transcription factor IID (TFIID), which binds to the core promoter to position the polymerase properly, serves as the scaffold for assembly of the remainder of the transcription complex, and acts as a channel for regulatory signals.
Specifications
| TAF15 | |
| Recombinant Monoclonal | |
| Unconjugated | |
| TAF15 | |
| 2610111C21Rik; 68 kDa TATA-binding protein-associated factor; 68kDa; hTAFII68; LOC100713096; Npl3; RBP56; RBP56/CSMF fusion; RNA-binding protein 56; TAF(II)68; Taf15; TAF15 RNA polymerase II, TATA box binding protein (TBP)-associated factor; TAF15 RNA polymerase II, TATA box binding protein (TBP)-associated factor, 68 kDa; TAF15 RNA polymerase II, TATA box binding protein (TBP)-associated factor, 68kDa; TAF2N; TAFII68; TATA box binding protein (TBP)-associated factor, RNA polymerase II, N, 68kD (RNA binding protein 56); TATA box binding protein (TBP)-associated factor, RNA polymerase II, N, 68kD (RNA-binding protein 56); TATA box binding protein associated factor 15; TATA box-binding protein-associated factor 2N (RNA-binding protein 56); TATA-bin; TATA-binding protein-associated factor 2N; TATA-box binding protein associated factor 15; TBP-associated factor 15 | |
| Rabbit | |
| Affinity chromatography | |
| RUO | |
| 287571, 70439, 8148 | |
| -20°C | |
| Liquid |
| Flow Cytometry, Western Blot, Immunocytochemistry | |
| 24GB1830 | |
| PBS with 50% glycerol and 0.02% sodium azide; pH 7.4 | |
| Q92804 | |
| TAF15 | |
| A synthesized peptide derived from human TAF15 (aa 565-592). | |
| 20 μL | |
| Primary | |
| Human, Mouse, Rat | |
| Antibody | |
| IgG |
Product Content Correction
Your input is important to us. Please complete this form to provide feedback related to the content on this product.
Product Title
Spot an opportunity for improvement?Share a Content Correction